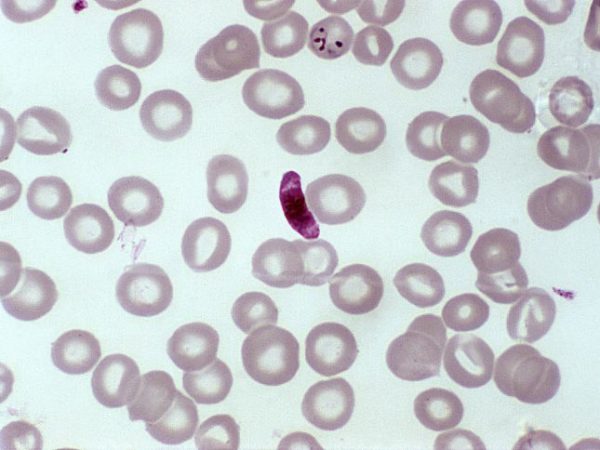

Ecology Internships Summer 2024 – You’ll gain professional experience through a funded internship, gaining knowledge Applications will open in February 2024. Applications for 2023 have now closed. Applications for summer 2024 will . SCSJ seeks legal interns to assist each of its three program areas — environmental justice, justice system reform, and voting rights during Summer 2024. Interns will assist have questions or .
Ecology Internships Summer 2024
Source : www.careermine.com
Best Summer Internships Abroad for Students 2024
Source : www.internhq.com
ELN Summer 2024 Internships – Thompson Earth Systems Institute
Source : www.floridamuseum.ufl.edu
Best Summer Internships Abroad for Students 2024
Source : www.internhq.com
Ecology Internships Passionist Earth & Spirit Center
Source : www.earthandspiritcenter.org
Biology and Ecology Internships Abroad CIS Abroad
Source : www.cisabroad.com
University of Lynchburg Environmental Sciences and Sustainability
Source : m.facebook.com
Summer Tropical Ecology + Conservation | Monteverde | CIEE
Source : www.ciee.org
Mississippi State University Marine Fisheries Ecology | Facebook
Source : www.facebook.com
Job Listing MSU Marine Fisheries Ecology Program 2024 Internship
Source : www.conservationjobboard.com
Ecology Internships Summer 2024 2024 Summer Internship Rangeland Ecology/Conservation Biology : Internships are a cornerstone of the undergraduate business experience. Vault recently revealed its 2024 Internship Rankings highlighting the top internship experiences across categories . The Lawyering Project is seeking three legal interns to support its legal programs during the summer of 2024. The legal internship is remote, and legal interns may choose to work from a minimum of .